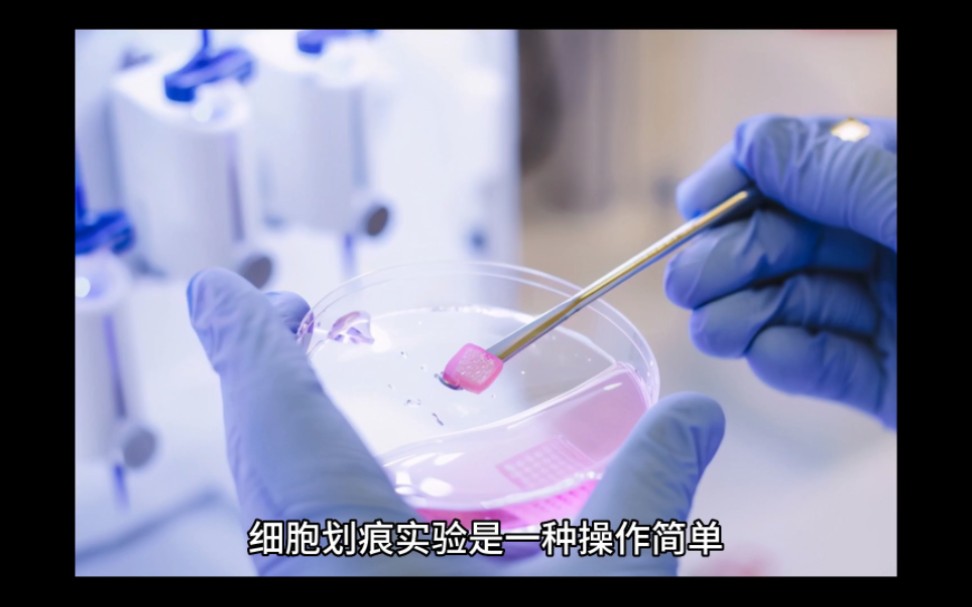
细胞划痕实验

划痕实验

"实验"的搜索结果_第三方检测机构|中化所
图片尺寸384x301
细胞划痕实验-赛业生物
图片尺寸547x399
细胞划痕实验的图片处理与面积计算(详细版)
图片尺寸960x600
原发性肝癌细胞中rock2调控mmp2对其侵袭迁移的作用
图片尺寸564x604
如何快速测量细胞划痕宽度?_pin
图片尺寸1080x1171
article info
图片尺寸951x452
细胞划痕实验怎么做?
图片尺寸1183x985
白色无釉瓷板瓷砖岩石矿物划痕刻划实验4年级白瓷片科学实验器材
图片尺寸800x800
环状rna hsa_circ_0091579对肝癌细胞增殖,迁移和侵袭的影响
图片尺寸700x360
i>rev-erbβ /i>基因敲除对肝癌hepg2细胞增殖和迁移侵袭的影响
图片尺寸700x261
6个小细节,轻松搞定细胞划痕实验
图片尺寸640x347
mir-92a在乳腺癌组织中表达及通过靶向调控klf4影响乳腺癌细胞的迁移
图片尺寸3346x1904
干货分享!细胞划痕实验新方法详解_ibidi
图片尺寸630x241
细胞划痕实验 - 合肥知恩生物
图片尺寸1271x1324
划痕实验-医思倍生物
图片尺寸869x501
划痕实验浅谈 - 知乎
图片尺寸457x332
细胞划痕实验原理介绍_step_处理_标准
图片尺寸826x297
细胞划痕实验
图片尺寸972x607
做实验 | "迁移攻略"之细胞划痕实验 - 知乎
图片尺寸520x404
解读文献里的那些图——细胞迁移实验_划痕
图片尺寸1080x998

























.jpg)